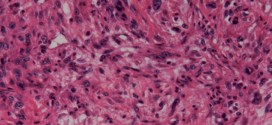

La parapsoriasis en placas. Otros nombres para esta patología: parapsoriasis; parapsoriasis digitiforme; parapsoriasis en placas pequeñas,; parapsoriasis poiquilodérmica; parapsoriasis en placas grandes. Parapsoriasis que se caracteriza por la presencia de grandes placas eritematosas (enrojecimiento difuso de la piel) en las extremidades y en el tronco. Las placas son ligeramente escamosas (laminas celulares de células epidérmicas que se desprende espontáneamente de …
Leer MásP
POIQUILODERMIA
La poiquilodermia. Dermatosis o alteración cutánea que se caracterizada tras serie de accidentes que semejas a una infección ligera, por la aparición de un eritema telangiectásico generalizado que forma una red de mallas capilares en cuyo centro la piel se atrofia. Localizado en la cara y el cuello de mujeres menopáusicas. Y un aspecto más o menos moteado. Pues bien …
Leer MásPLEXO CELÍACO
El plexo celíaco. Plexo nervioso simpático que se origina por el entrecruzamiento de las ramas eferentes de los ganglios semilunares. Se encarga de inervar los órganos abdominales. Para todas estas patologías la madre naturaleza nos regala sus dones más preciados para nuestra salud y recuperación y bienestar o al menos para tener una vida más digna… Información: Antes de nada …
Leer MásPROSTATISMO
El prostatismo. Estado general y mental provocado por enfermedades de la próstata, especialmente retención urinaria por hipertrofia del órgano. Si fuese de su deseo le podemos elaborar un plan trofológico personalizado para usted. Ver en prostatitis.
Leer MásPOLIOSIS
La poliosis. Canicie (canas) prematura, aparición prematura de cabellos grises en el cuero cabelludo o en otras partes del sistema piloso en el cuerpo. Pues bien una vez diagnosticado cual es la enfermedad o nombre de dicha patología, lo primero que debería de hacer es él no abusar en cremas o pomadas externas. De lo contrario corre el peligro de …
Leer MásPENFIGOIDE
El penfigoide. Es una enfermedad autoinmune ampollosa crónica (a saber), que suele aparecer en individuos ancianos y que se acompaña de un intenso prurito (picor). A diferencia del pénfigo, la afectación sistémica y la extensión de la afectación cutánea son menores. La localización de las ampollas desde el punto de vista histológico es subepidérmica, por lo que las ampollas se …
Leer MásPÁPULA
La pápula. Elevación eruptiva epitelial de pequeño tamaño sólida circunscrita de la piel y más o menos redondeada que se eleva sobre el nivel de la piel y cuya consistencia es dura. Está provocada por un aumento de las células de la epidermis, de la dermis o de ambas que ordinariamente termina por descamación y aparece en muchas afecciones dermatológicas …
Leer MásPARAPSORIASIS
La parapsoriasis. Para un conjunto o grupo de desórdenes caracterizado por una erupción inflamatoria persistente y escamosa. Se diferencian de otras dermatitis inflamatorias por su relación con lesiones linfoproliferativas malignas y la coexistencia o superposición de lesiones de este tipo. Aspecto del tipo de la psoriasiforme, liquenoide, macupapulosa, etc, de acción muy rebelde a los tratamientos oficiales. Que suelen olvidar …
Leer MásPÚRPURA
La púrpura. Afección caracterizada por la formación de manchas rojas o azuladas en la piel constituidas por diminutos extravasados sanguíneos subcutáneos de hemorragia de eritrocitos en la piel o en mucosas que provoca la aparición de pequeñas manchas rojas. La púrpura suele estar causada por algún tipo de crisis sanguínea (trombopenia), sintomas de enfermedades diversas o traumatismos. Pues bien una …
Leer MásPSEUDOLINFOMA CUTÁNEO
El pseudolinfoma cutáneo. Tumor maligno ó manchas malignas en general y especialmente el formado por células epiteliales o pigmentarias. Los canceres se dividen en dos grandes categorías de carcinoma y sarcoma. La característica básica de la malignidad es una anormalidad de las células, trasmitida a las células hijas, a saber, que se manifiesta por la reducción del control del crecimiento …
Leer MásPECA MELANÓTICA DE HUTCHINSON
La peca melanótica de Hutchinson. Tumor maligno ó manchas malignas en general y especialmente el formado por células epiteliales o pigmentarias. Los canceres se dividen en dos grandes categorías de carcinoma y sarcoma. La característica básica de la malignidad es una anormalidad de las células, trasmitida a las células hijas, a saber, que se manifiesta por la reducción del control …
Leer MásTUMORES MALIGNOS DE PRÓSTATA
Los tumores malignos de próstata. Publicado en: binipatia.com Escrito por: Salvador Gregori y Abby Schaffner Etiquetas: sustancias súper nutritivas, tratamiento natural, reishi, vitamina D3 Resumiendo: La próstata es un órgano del sistema reproductor del varón. Es una glándula, con forma de castaña, colocada debajo de la vejiga y por delante del recto. La uretra (conducto por donde sale la orina) atraviesa la …
Leer MásAGRANDAMIENTO DE LA PRÓSTATA
La próstata, suele dar problemas en los hombres en partir de los 47-50 años, no todos por igual eso que quede claro. La causa más numerosa de pacientes es por la hiperplasia benigna de próstata (HPB). El agrandamiento de la próstata, se refiere que se agranda (aumenta de tamaño), con lo cual hay los problemas para poder orinar o dificulta …
Leer MásPAQUIDERMIA VORTICILADA DEL CUERO CABELLUDO
La paquidermia vorticilada del cuero cabelludo. Nevo de gran tamaño que afecta al cuero cabelludo; hipertrofia o engrosamiento del cuero cabelludo que está formado por repliegues contorneados y surcos profundos. ver en: paquidermia. Si fuese de su deseo le podemos elaborar un plan trofológico personalizado para usted. Para una información completa póngase en contacto con nosotros. Ver información completa. o …
Leer MásPAQUIDERMIA
La paquidermia. Hipertrofia es el espesamiento anormal o patológico de la piel, por causas diversas, como edemas o inflamaciones crónicas, etc. La hipertrofia de la piel y tejido subcutáneo, puede alcanzar a veces proporciones anormales grandes del espesor de la piel. Pues bien una vez diagnosticado cual es la enfermedad o nombre de dicha patología, lo primero que debería de …
Leer MásPÉNFIGO
El pénfigo. Es la enfermedad ampollosa más grave. Es una de las pocas enfermedades de la piel que conlleva peligro para la vida del paciente. Su origen es autoinmune y afecta la piel y las mucosas. El fenómeno etiopatogénica causante de esta enfermedad es la perdida de la cohesión entre células epidérmicas y como consecuencia, se origina la formación de …
Leer MásPARÁLISIS DE ARAN-DUCHENNE
La parálisis de aran-duchenne. Atrofia muscular progresiva mielógena con afección de las raíces nerviosas octava cervical y primera dorsal, con afectación de las neuronas motoras. Producen parálisis fláccida y atrofias musculares de los flexores de los dedos y el cubital anterior, entre otros. Afecciones del sistema nervioso central, cerebral, etc, de probable patogenia autoinmune, etc, que se caracteriza por placas …
Leer MásCARCINOSARCOMA DE PRÓSTATA
El carcinosarcoma de próstata. Publicado en: binipatia.com Escrito por: Salvador Gregori Escrivá y IJosh Bush Etiquetas: sustancias súper nutritivas, promover la salud verdadera, arsenal terapéutico alternativo Se trata del tumor maligno más frecuente en los seres humanos. En varones. Durante los primeros años de vida de una persona, las células normales se dividen más rápidamente para permitir el crecimiento. El cuerpo está …
Leer MásPAPILOMA
El papiloma. Hipertrofia de las papilas de una superficie cutánea o mucosa. Tumor epitelial benigno que se presenta como una excrecencia de superficie irregular y diversos tamaños. Neoplasia epitelial benigna que presenta una disposición ramificada o lobulillar. Se produce en la piel especialmente de manos y pies y por lesiones en las membranas mucosas de la boca y de las …
Leer MásPROSTATITIS
La prostatitis. Infamación aguda o crónica de la próstata. Puede ser bacteriana aguda no asociada a sondaje se suele deber a los microorganismos urinarios habituales gran negativo (E. coli o klebsiella). En los casos asociados al sondaje pueden estar implicados bacilos gran negativos hospitalarios o enterococos. E. coli, klebsiella y proteus también causan prostatitis crónica. Las manifestaciones clínicas en la …
Leer Más Binipatia e higienismo Medicina natural alternativa, plantas medicinales y remedios caseros naturales
Binipatia e higienismo Medicina natural alternativa, plantas medicinales y remedios caseros naturales